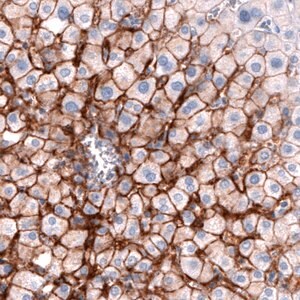
Merck Monoclonal Anti-SLCO1B3 antibody produced in mouse

Merck Monoclonal Anti-SLCO1B3 antibody produced in mouse
상품 한눈에 보기
인간 SLCO1B3 단백질을 인식하는 mouse monoclonal 항체. Prestige Antibodies® 시리즈로 Atlas Antibodies 기술 적용. 정제된 immunoglobulin 형태이며 immunohistochemistry에 적합. −20°C에서 보관, wet ice로 배송.
브랜드: Merck Sigma
✨AI 추천 연관 상품
AI가 분석한 이 상품과 연관된 추천 상품들을 확인해보세요
연관 상품을 찾고 있습니다...
Monoclonal Anti-SLCO1B3 antibody produced in mouse
Prestige Antibodies® Powered by Atlas Antibodies
Clone CL3770, purified immunoglobulin, buffered aqueous glycerol solution
제품 개요
- 항체 유형: Primary monoclonal antibody
- 생물학적 소스: Mouse
- 클론: CL3770
- 결합 상태: Unconjugated
- 형태: Purified immunoglobulin in buffered aqueous glycerol solution
- 제품 라인: Prestige Antibodies® Powered by Atlas Antibodies
기술 정보
| 항목 | 내용 |
|---|---|
| Species reactivity | Human |
| 포장 | 25 μL (small pack) |
| Technique(s) | Immunohistochemistry (1:200–1:500) |
| 동형 | IgG1 |
| 면역원 서열 | QGKDTKASDNERKVMDEANLEFLNNGEHFVPSAGTDSKTCNLDMQDNAAA |
| UniProt 수납 번호 | Q9NPD5 |
| 배송 상태 | Wet ice |
| 저장 온도 | −20°C |
Gene Information
- Gene: SLCO1B3 (solute carrier organic anion transporter family, member 1B3)
- Species: Human
- Gene ID: SLCO1B3 (28234)
품질 등급
Quality Level: 100 (M-Clarity Program 기준)
🏷️Merck Sigma 상품 둘러보기
동일 브랜드의 다른 상품들을 확인해보세요

Merck Sigma
Merck Anti-IL1R1 antibody produced in rabbit
817,800원

Merck Sigma
Merck Monoclonal Anti-LMNB1 antibody produced in mouse
817,800원

Merck Sigma
Merck Monoclonal Anti-SLCO1B3 antibody produced in mouse
671,800원

Merck Sigma
Merck Monoclonal Anti-GRHL2 antibody produced in mouse
671,800원

Merck Sigma
Merck Monoclonal Anti-SLCO1B3 antibody produced in mouse
671,800원
배송/결제/교환/반품 안내
배송 정보
| 기본 배송비 |
| 교환/반품 배송비 |
|
|---|---|---|---|
| 착불 배송비 |
| ||
| 교환/반품 배송비 |
| ||
결제 및 환불 안내
| 결제수단 |
|
|---|---|
| 취소 |
|
| 반품 |
|
| 환급 |
|
교환 및 반품 접수
| 교환 및 반품 접수 기한 |
|
|---|---|
| 교환 및 반품 접수가 가능한 경우 |
|
| 교환 및 반품 접수가 불가능한 경우 |
|
교환 및 반품 신청
| 교환 절차 |
|
|---|---|
| 반품 절차 |
|
문의 0
로그인 후 문의를 할 수 있습니다.